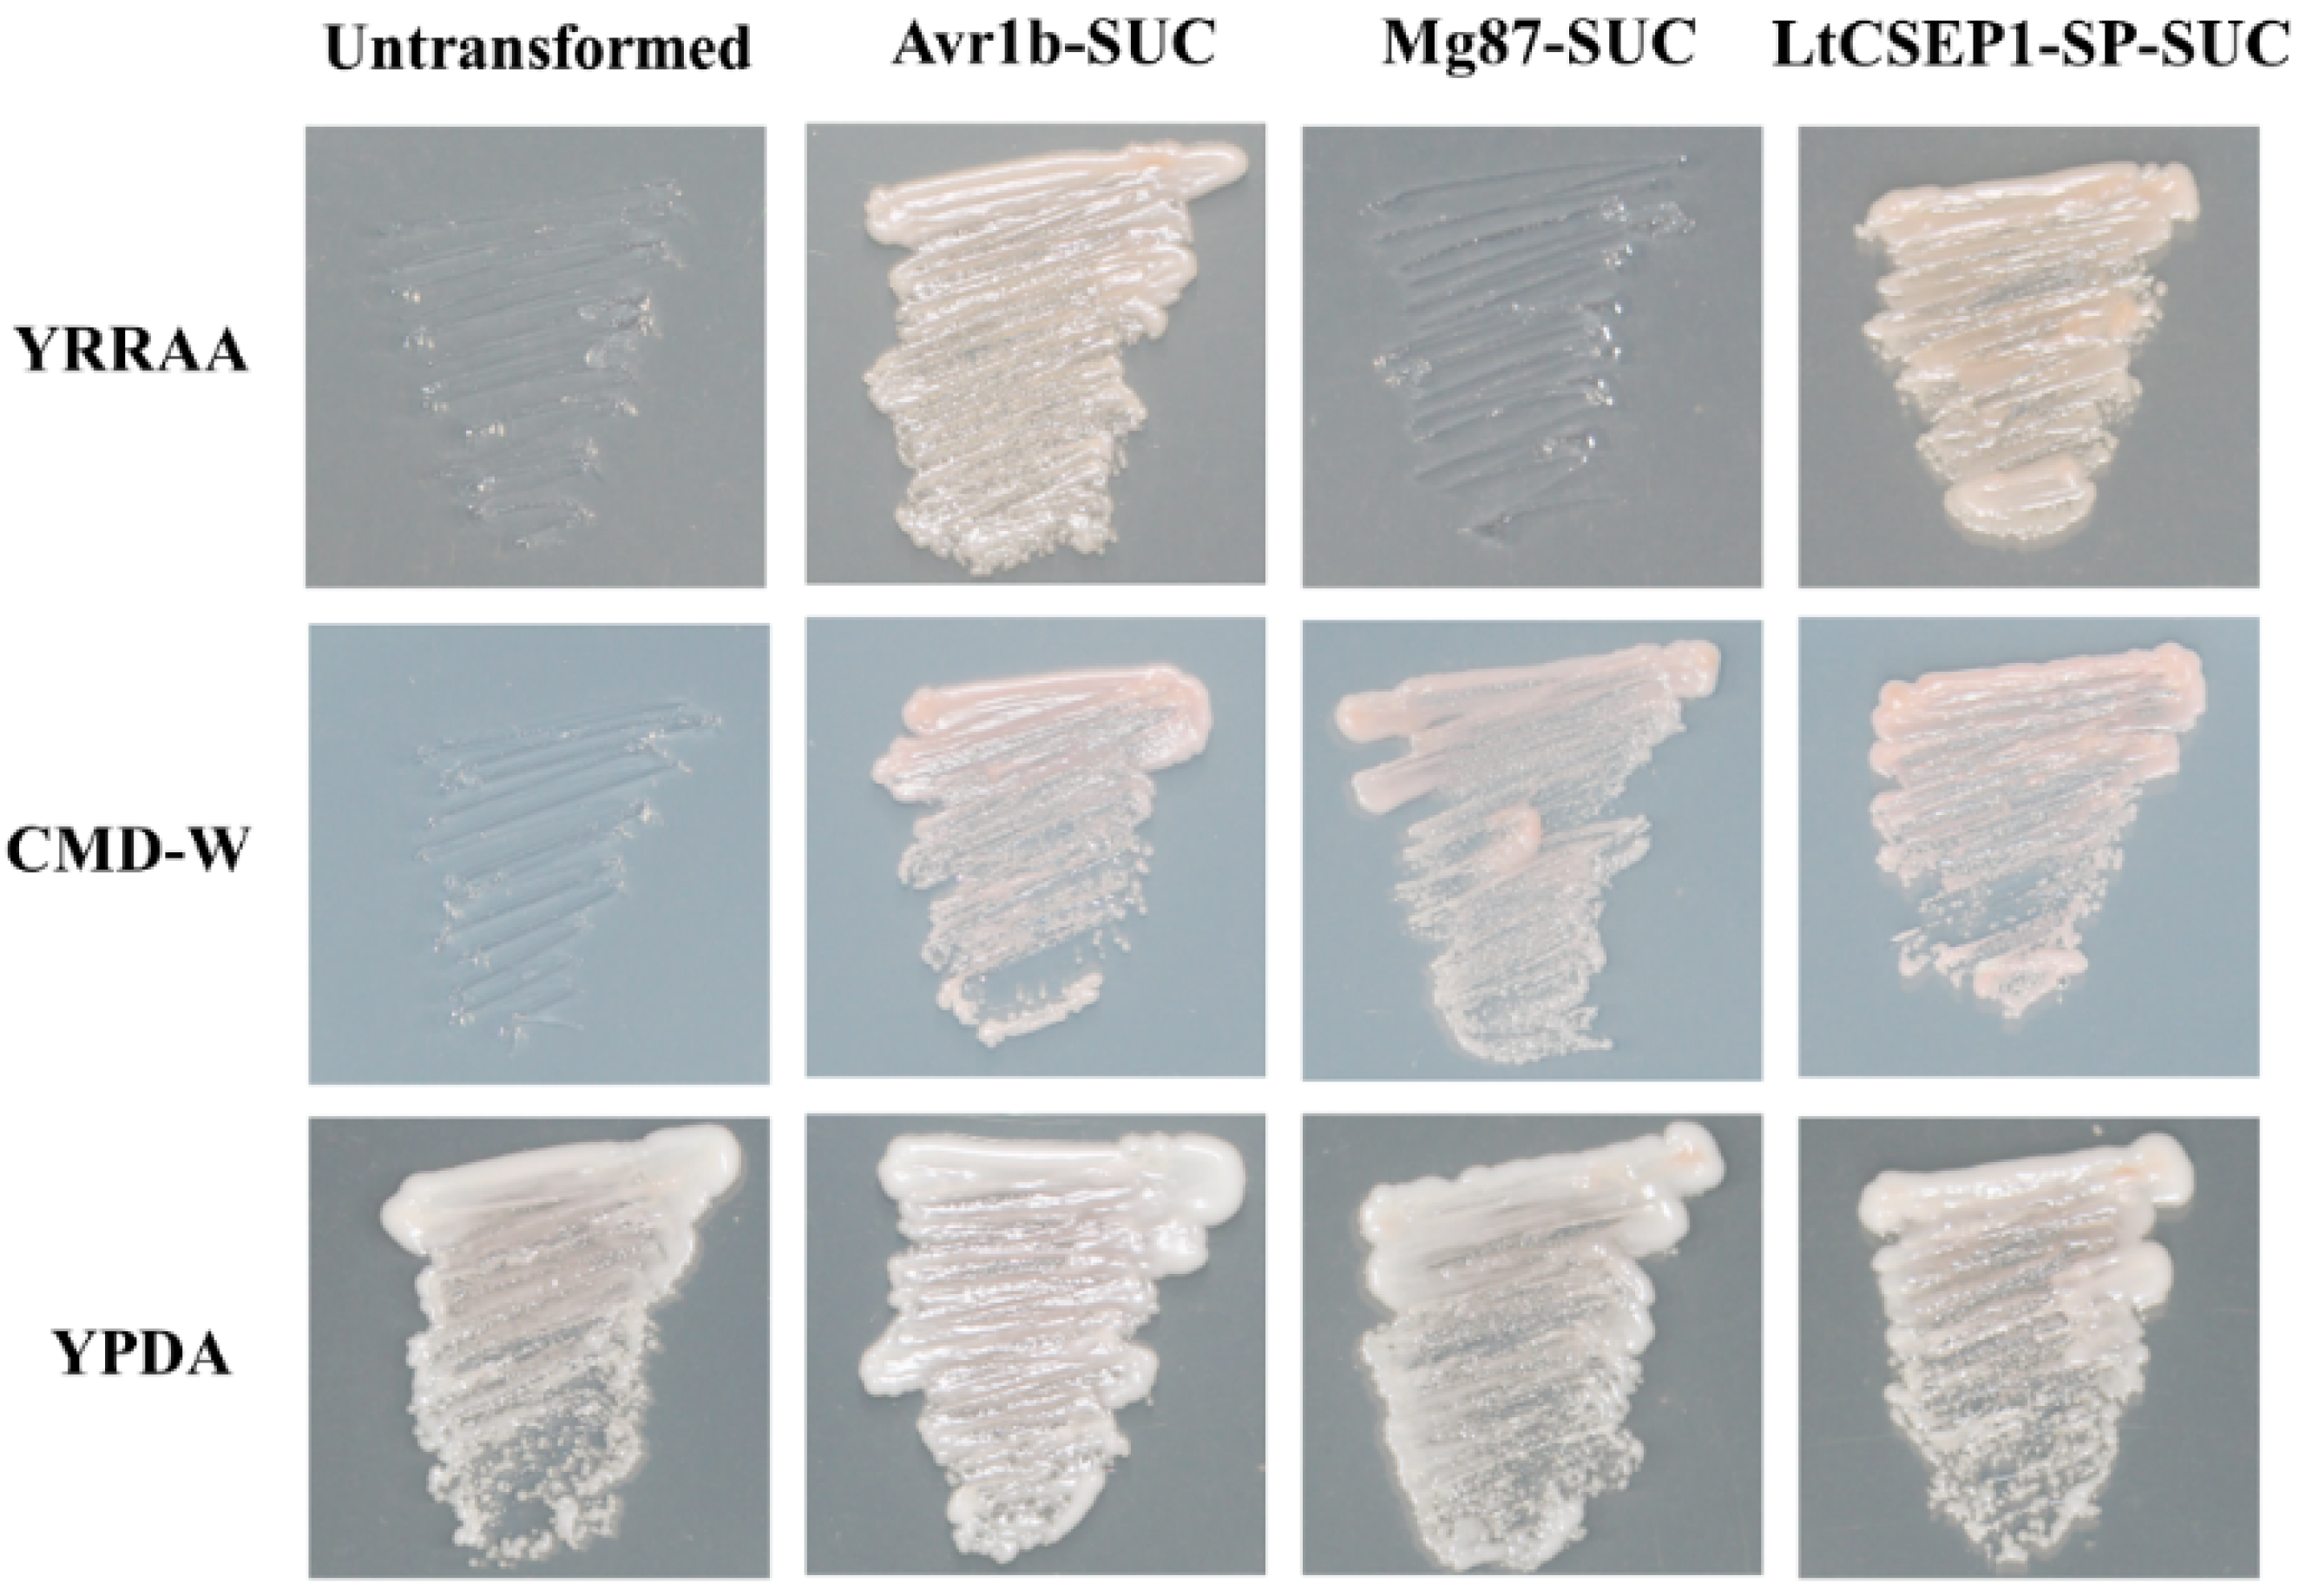

A Putative Effector LtCSEP1 from Lasiodiplodia theobromae Inhibits BAX-Triggered Cell Death and Suppresses Immunity Responses in Nicotiana benthamiana
Abstract
:1. Introduction
2. Results
2.1. LtCSEP1 Is Transcriptionally Up-Regulated during Lasiodiplodia theobromae Infection
2.2. LtCSEP1 Encodes a Secretory Effector Protein
2.3. LtCSEP1 Suppresses BAX-Induced Cell Death in Nicotiana benthamiana
2.4. LtCSEP1 Suppresses flg22-Triggered PTI in N. benthamiana
2.5. LtCSEP1 Expression Enhances Plant Susceptibility to Lasiodiplodia theobromae
3. Discussion
4. Materials and Methods
4.1. Fungal and Bacterial Isolates, Plant Materials, and Growth Conditions
4.2. Lasiodiplodia theobromae Inoculation
4.3. RNA Isolation and Quantitative Real-Time RT-PCR
4.4. Cloning of the LtCSEP1 cDNA Sequence
4.5. Functional Validation of the Predicted Signal Peptide Using Yeast Secretion Assay
4.6. Cell-Death Suppression Assay in Nicotiana Benthamiana
4.7. PTI-Associated Gene Expression and ROS Assays in Nicotiana benthamiana
4.8. Nicotiana benthamiana Transformation and Pathogenicity Assays for L. theobromae
4.9. Protein Extraction and Western Blot
Supplementary Materials
Author Contributions
Funding
Institutional Review Board Statement
Informed Consent Statement
Data Availability Statement
Acknowledgments
Conflicts of Interest
References
- Adam-Blondon, A.F.; Alaux, M.; Pommier, C.; Cantu, D.; Cheng, Z.M.; Cramer, G.R.; Davies, C.; Delrot, S.; Deluc, L.; Gaspero, G.D.; et al. Towards an open grapevine information system. Hortic. Res. 2016, 3, 16056. [Google Scholar] [CrossRef] [Green Version]
- Héloir, M.C.; Adrian, M.; Brulé, D.; Claverie, J.; Cordelier, S.; Daire, X.; Dorey, S.; Gauthier, A.; Lemaître-Guillier, C.; Negrel, J.; et al. Recognition of elicitors in grapevine: From MAMP and DAMP perception to induced resistance. Front. Plant Sci. 2019, 10, 1117. [Google Scholar] [CrossRef]
- Dissanayake, A.J.; Phillips, A.J.L.; Li, X.; Hyde, K.D. Botryosphaeriaceae: Current status of genera and species. Mycosphere 2016, 7, 1001–1073. [Google Scholar] [CrossRef]
- Yang, T.; Groenewald, J.Z.; Cheewangkoon, R.; Jami, F.; Abdollahzadeh, J.; Lombard, L.; Crous, P.W. Families, genera, and species of Botryosphaeriales. Fungal Biol. 2017, 121, 322–346. [Google Scholar] [CrossRef] [PubMed]
- Songy, A.; Fernandez, O.; Clément, C.; Larignon, P.; Fontaine, F. Grapevine trunk diseases under thermal and water stresses. Planta 2019, 249, 1655–1679. [Google Scholar] [CrossRef] [PubMed]
- Guan, P.; Schmidt, F.; Riemann, M.; Fischer, J.; Thines, E.; Nick, P. Hunting modulators of plant defence: The grapevine trunk disease fungus Eutypa lata secretes an amplifier for plant basal immunity. J. Exp. Bot. 2020, 71, 3710–3724. [Google Scholar] [CrossRef] [PubMed]
- Úrbez-Torres, J.R. The status of Botryosphaeriaceae species infecting grapevines. Phytopathol. Mediterr. 2011, 50, S5–S45. [Google Scholar]
- Yan, J.; Xie, Y.; Zhang, W.; Wang, Y.; Liu, J.; Hyde, K.D.; Seem, R.C.; Zhang, G.; Wang, Z.; Yao, S.; et al. Species of Botryosphaeriaceae involved in grapevine dieback in China. Fungal Divers. 2013, 61, 221–236. [Google Scholar] [CrossRef]
- Carlucci, A.; Cibelli, F.; Lops, F.; Raimondo, M.L. Characterization of Botryosphaeriaceae species as causal agents of trunk diseases on grapevines. Plant Dis. 2015, 99, 1678–1688. [Google Scholar] [CrossRef] [Green Version]
- Gonçalves, M.F.M.; Nunes, R.B.; Tilleman, L.; de Peer, Y.V.; Deforce, D.; Nieuwerburgh, F.V.; Esteves, A.C.; Alves, A. Dual RNA sequencing of Vitis vinifera during Lasiodiplodia theobromae infection unveils host–pathogen interactions. Int. J. Mol. Sci. 2019, 20, 6083. [Google Scholar] [CrossRef] [Green Version]
- Félix, C.; Meneses, R.; Gonçalves, M.F.M.; Tilleman, L.; Duarte, A.S.; Jorrín-Novo, J.V.; de Peer, Y.V.; Deforce, D.; Nieuwerburgh, F.V.; Esteves, A.C.; et al. A multi-omics analysis of the grapevine pathogen Lasiodiplodia theobromae reveals that temperature affects the expression of virulence-and pathogenicity-related genes. Sci. Rep. 2019, 9, 13144. [Google Scholar] [CrossRef] [PubMed] [Green Version]
- Zhang, H.; Shen, W.; Zhang, D.; Shen, X.; Wang, F.; Hsiang, T.; Liu, J.; Li, G. The bZIP Transcription factor LtAP1 modulates oxidative stress tolerance and virulence in the peach gummosis fungus Lasiodiplodia theobromae. Front. Microbiol. 2021, 12, 741842. [Google Scholar] [CrossRef] [PubMed]
- Makatini, G.; Mutawila, C.; Halleen, F.; Mostert, L. Grapevine sucker wounds as infection ports for trunk disease pathogens. Phytopathol. Mediterr. 2014, 53, 573. [Google Scholar]
- Spagnolo, A.; Magnin-Robert, M.; Alayi, T.D.; Cilindre, C.; Schaeffer-Reiss, C.; Dorsselaer, A.V.; Clément, C.; Larignon, P.; Ramirez-Suero, M.; Chong, J.; et al. Differential responses of three grapevine cultivars to Botryosphaeria dieback. Phytopathology 2014, 104, 1021–1035. [Google Scholar] [CrossRef] [PubMed] [Green Version]
- Chethana, K.W.T.; Li, X.; Zhang, W.; Hyde, K.D.; Yan, J. Trail of decryption of molecular research on Botryosphaeriaceae in woody plants. Phytopathol. Mediterr. 2016, 55, 147–171. [Google Scholar]
- Jones, J.D.G.; Dangl, J.L. The plant immune system. Nature 2006, 444, 323–329. [Google Scholar] [CrossRef] [Green Version]
- Zhang, J.; Coaker, G.; Zhou, J.; Dong, X. Plant immune mechanisms: From reductionistic to holistic points of view. Mol. Plant 2020, 13, 1358–1378. [Google Scholar] [CrossRef]
- Yuan, M.; Ngou, B.P.M.; Ding, P.; Xin, X. PTI-ETI crosstalk: An integrative view of plant immunity. Curr. Opin. Plant Biol. 2021, 62, 102030. [Google Scholar] [CrossRef]
- Dou, D.; Zhou, J. Phytopathogen effectors subverting host immunity: Different foes, similar battleground. Cell Host Microbe 2012, 12, 484–495. [Google Scholar] [CrossRef] [Green Version]
- Franceschetti, M.; Maqbool, A.; Jiménez-Dalmaroni, M.J.; Pennington, H.G.; Kamoun, S.; Banfield, M.J. Effectors of filamentous plant pathogens: Commonalities amid diversity. Microbiol. Mol. Biol. Rev. 2017, 81, e00066-16. [Google Scholar] [CrossRef] [Green Version]
- Ward, R.A.; Vyas, J.M. The first line of defense: Effector pathways of anti-fungal innate immunity. Curr. Opin. Microbiol. 2020, 58, 160–165. [Google Scholar] [CrossRef] [PubMed]
- Pradhan, A.; Ghosh, S.; Sahoo, D.; Jha, G. Fungal effectors, the double edge sword of phytopathogens. Curr. Genet. 2021, 67, 27–40. [Google Scholar] [CrossRef] [PubMed]
- Cook, D.E.; Mesarich, C.H.; Thomma, B.P.H.J. Understanding plant immunity as a surveillance system to detect invasion. Annu. Rev. Phytopathol. 2015, 53, 541–563. [Google Scholar] [CrossRef] [PubMed]
- Rodriguez-Moreno, L.; Ebert, M.K.; Bolton, M.D.; Thomma, B.P.H.J. Tools of the crook-infection strategies of fungal plant pathogens. Plant J. 2018, 93, 664–674. [Google Scholar] [CrossRef] [PubMed] [Green Version]
- Giraldo, M.C.; Valent, B. Filamentous plant pathogen effectors in action. Nat. Rev. Microbiol. 2013, 11, 800–814. [Google Scholar] [CrossRef]
- Wang, X.; Jiang, N.; Liu, J.; Liu, W.; Wang, G. The role of effectors and host immunity in plant–necrotrophic fungal interactions. Virulence 2014, 5, 722–732. [Google Scholar] [CrossRef] [Green Version]
- Toruño, T.Y.; Stergiopoulos, I.; Coaker, G. Plant-pathogen effectors: Cellular probes interfering with plant defenses in spatial and temporal manners. Annu. Rev. Phytopathol. 2016, 54, 419–441. [Google Scholar] [CrossRef] [Green Version]
- Salvatore, M.M.; Alves, A.; Andolfi, A. Secondary metabolites of Lasiodiplodia theobromae: Distribution, chemical diversity, bioactivity, and implications of their occurrence. Toxins 2020, 12, 457. [Google Scholar] [CrossRef]
- Zhang, Y.; Zhang, K.; Fang, A.; Han, Y.; Yang, J.; Xue, M.; Bao, J.; Hu, D.; Zhou, B.; Sun, X.; et al. Specific adaptation of Ustilaginoidea virens in occupying host florets revealed by comparative and functional genomics. Nat. Commun. 2014, 5, 3849. [Google Scholar] [CrossRef] [Green Version]
- Yin, X.; Liu, R.; Su, H.; Su, L.; Guo, Y.; Wang, Z.; Du, W.; Li, M.; Zhang, X.; Wang, Y.; et al. Pathogen development and host responses to Plasmopara viticola in resistant and susceptible grapevines: An ultrastructural study. Hortic. Res. 2017, 4, 17033. [Google Scholar] [CrossRef]
- Valero-Jiménez, C.A.; Veloso, J.; Staats, M.; van Kan, J.A.L. Comparative genomics of plant pathogenic Botrytis species with distinct host specificity. BMC Genom. 2019, 20, 203. [Google Scholar] [CrossRef] [PubMed] [Green Version]
- Medema, M.H.; Rond, T.D.; Moore, B.S. Mining genomes to illuminate the specialized chemistry of life. Nat. Rev. Genet. 2021, 22, 553–571. [Google Scholar] [CrossRef] [PubMed]
- Yan, J.; Zhao, W.; Chen, Z.; Xing, Q.; Zhang, W.; Chethana, K.W.T.; Xue, M.; Xu, J.; Phillips, A.J.L.; Wang, Y.; et al. Comparative genome and transcriptome analyses reveal adaptations to opportunistic infections in woody plant degrading pathogens of Botryosphaeriaceae. DNA Res. 2018, 25, 87–102. [Google Scholar] [CrossRef] [PubMed] [Green Version]
- Xing, Q.; Li, L.; Cao, Y.; Zhang, W.; Peng, J.; Yan, J.; Li, X. Prediction and analysis of candidate secreted proteins from the genome of Lasiodiplodia theobromae. Sci. Agric. Sin. 2020, 53, 5027–5038. [Google Scholar]
- Chethana, K.W.T.; Peng, J.; Li, X.; Xing, Q.; Liu, M.; Zhang, W.; Hyde, K.D.; Zhao, W.; Yan, J. LtEPG1, a secretory endopolygalacturonase protein, regulates the virulence of Lasiodiplodia theobromae in Vitis vinifera and is recognized as an MAMP. Phytopathology 2020, 110, 1727–1736. [Google Scholar] [CrossRef]
- Xing, Q.; Yan, J.; Zhang, W.; Liu, M.; Fu, C.; Li, X. Construction of a yeast two-hybrid cDNA library from tobacco leaves infected by Lasiodiplodia theobromae. Acta Phytopathol. Sin. 2017, 47, 716–720. [Google Scholar]
- Jacobs, K.A.; Collins-Racie, L.A.; Colbert, M.; Duckett, M.; Golden-Fleet, M.; Kelleher, K.; Kriz, R.; LaVallie, E.R.; Merberg, D.; Spaulding, V.; et al. A genetic selection for isolating cDNAs encoding secreted proteins. Gene 1997, 198, 289–296. [Google Scholar] [CrossRef]
- Fang, A.; Han, Y.; Zhang, N.; Zhang, M.; Liu, L.; Li, S.; Lu, F.; Sun, W. Identification and characterization of plant cell death–inducing secreted proteins from Ustilaginoidea virens. Mol. Plant-Microbe Interact. 2016, 29, 405–416. [Google Scholar] [CrossRef] [Green Version]
- Lacomme, C.; Cruz, S.S. Bax-induced cell death in tobacco is similar to the hypersensitive response. Proc. Natl. Acad. Sci. USA 1999, 96, 7956–7961. [Google Scholar] [CrossRef] [Green Version]
- Wang, Q.; Han, C.; Ferreira, A.O.; Yu, X.; Ye, W.; Tripathy, S.; Kale, S.D.; Gu, B.; Sheng, Y.; Sui, Y.; et al. Transcriptional programming and functional interactions within the Phytophthora sojae RXLR effector repertoire. Plant Cell 2011, 23, 2064–2086. [Google Scholar] [CrossRef] [Green Version]
- Chen, C.; Liu, S.; Liu, Q.; Niu, J.; Liu, P.; Zhao, J.; Jian, H. An ANNEXIN-like protein from the cereal cyst nematode Heterodera avenae suppresses plant defense. PLoS ONE 2015, 10, e0122256. [Google Scholar] [CrossRef] [PubMed] [Green Version]
- Dalio, R.J.D.; Herlihy, J.; Oliveira, T.S.; McDowell, J.M.; Machado, M. Effector biology in focus: A primer for computational prediction and functional characterization. Mol. Plant-Microbe Interact. 2018, 31, 22–33. [Google Scholar] [CrossRef] [PubMed]
- Stergiopoulos, I.; de Wit, P.J.G.M. Fungal effector proteins. Annu. Rev. Phytopathol. 2009, 47, 233–263. [Google Scholar] [CrossRef] [PubMed] [Green Version]
- Ramachandran, S.R.; Yin, C.; Kud, J.; Tanaka, K.; Mahoney, A.K.; Xiao, F.; Hulbert, S.H. Effectors from wheat rust fungi suppress multiple plant defense responses. Phytopathology 2016, 107, 75–83. [Google Scholar] [CrossRef] [PubMed] [Green Version]
- Chen, C.; Chen, Y.; Jian, H.; Yang, D.; Dai, Y.; Pan, L.; Shi, F.; Yang, S.; Liu, Q. Large-scale identification and characterization of Heterodera avenae putative effectors suppressing or inducing cell death in Nicotiana benthamiana. Front. Plant Sci. 2018, 8, 2062. [Google Scholar] [CrossRef] [PubMed] [Green Version]
- Zhang, C.J.; Wang, S.X.; Liang, Y.N.; Wen, S.; Dong, B.; Ding, Z.; Guo, L.; Zhu, X. Candidate effectors from Botryosphaeria dothidea suppress plant immunity and contribute to virulence. Int. J. Mol. Sci. 2021, 22, 552. [Google Scholar] [CrossRef]
- Li, Z.; Yin, Z.; Fan, Y.; Xu, M.; Kang, Z.; Huang, L. Candidate effector proteins of the necrotrophic apple canker pathogen Valsa mali can suppress BAX-induced PCD. Front. Plant Sci. 2015, 6, 579. [Google Scholar] [CrossRef] [Green Version]
- Zhao, J.; Li, L.; Liu, Q.; Liu, P.; Li, S.; Yang, D.; Chen, Y.; Pagnotta, S.; Favery, B.; Abad, P.; et al. A MIF-like effector suppresses plant immunity and facilitates nematode parasitism by interacting with plant annexins. J. Exp. Bot. 2019, 70, 5943–5958. [Google Scholar] [CrossRef]
- Zhang, M.; Rajput, N.A.; Shen, D.; Sun, P.; Zeng, W.; Liu, T.; Mafurah, J.J.; Dou, D. A phytophthora sojae cytoplasmic effector mediates disease resistance and abiotic stress tolerance in Nicotiana benthamiana. Sci. Rep. 2015, 5, 10837. [Google Scholar] [CrossRef] [Green Version]
- Nasir, A.R.; Zhang, M.; Shen, D.; Liu, T.; Zhang, Q.; Ru, Y.; Sun, P.; Dou, D. Overexpression of a phytophthora cytoplasmic CRN effector confers resistance to disease, salinity and drought in Nicotiana benthamiana. Plant Cell Physiol. 2015, 56, 2423–2435. [Google Scholar]
- Bürger, M.; Chory, J. Stressed out about hormones: How plants orchestrate immunity. Cell Host Microbe 2019, 26, 163–172. [Google Scholar] [CrossRef] [PubMed]
- Shen, Q.; Liu, Y.; Naqvi, N.I. Fungal effectors at the crossroads of phytohormone signaling. Curr. Opin. Microbiol. 2018, 46, 1–6. [Google Scholar] [CrossRef] [PubMed]
- Dean, J.D.; Goodwin, P.H.; Hsiang, T. Induction of glutathione S-transferase genes of Nicotiana benthamiana following infection by Colletotrichum destructivum and C. orbiculare and involvement of one in resistance. J. Exp. Bot. 2005, 56, 1525–1533. [Google Scholar] [CrossRef] [PubMed] [Green Version]
- Asai, S.; Yoshioka, H. Nitric oxide as a partner of reactive oxygen species participates in disease resistance to necrotrophic pathogen Botrytis cinerea in Nicotiana benthamiana. Mol. Plant-Microbe Interact. 2009, 22, 619–629. [Google Scholar] [CrossRef] [Green Version]
- Xiang, J.; Li, X.; Yin, L.; Liu, Y.; Zhang, Y.; Qu, J.; Lu, J. A candidate RxLR effector from Plasmopara viticola can elicit immune responses in Nicotiana benthamiana. BMC Plant Biol. 2017, 17, 75. [Google Scholar] [CrossRef] [Green Version]
- Livak, K.J.; Schmittgen, T.D. Analysis of relative gene expression data using real-time quantitative PCR and the 2−ΔΔCT method. Methods 2001, 25, 402–408. [Google Scholar] [CrossRef]
- Gallois, P.; Marinho, P. Leaf disk transformation using Agrobacterium tumefaciens-expression of heterologous genes in tobacco. Methods Mol. Biol. 1995, 49, 39–48. [Google Scholar]

Publisher’s Note: MDPI stays neutral with regard to jurisdictional claims in published maps and institutional affiliations. |
© 2022 by the authors. Licensee MDPI, Basel, Switzerland. This article is an open access article distributed under the terms and conditions of the Creative Commons Attribution (CC BY) license (https://creativecommons.org/licenses/by/4.0/).
Share and Cite
Xing, Q.; Cao, Y.; Peng, J.; Zhang, W.; Wu, J.; Zhou, Y.; Li, X.; Yan, J. A Putative Effector LtCSEP1 from Lasiodiplodia theobromae Inhibits BAX-Triggered Cell Death and Suppresses Immunity Responses in Nicotiana benthamiana. Plants 2022, 11, 1462. https://doi.org/10.3390/plants11111462
Xing Q, Cao Y, Peng J, Zhang W, Wu J, Zhou Y, Li X, Yan J. A Putative Effector LtCSEP1 from Lasiodiplodia theobromae Inhibits BAX-Triggered Cell Death and Suppresses Immunity Responses in Nicotiana benthamiana. Plants. 2022; 11(11):1462. https://doi.org/10.3390/plants11111462
Chicago/Turabian StyleXing, Qikai, Yang Cao, Junbo Peng, Wei Zhang, Jiahong Wu, Yueyan Zhou, Xinghong Li, and Jiye Yan. 2022. "A Putative Effector LtCSEP1 from Lasiodiplodia theobromae Inhibits BAX-Triggered Cell Death and Suppresses Immunity Responses in Nicotiana benthamiana" Plants 11, no. 11: 1462. https://doi.org/10.3390/plants11111462
APA StyleXing, Q., Cao, Y., Peng, J., Zhang, W., Wu, J., Zhou, Y., Li, X., & Yan, J. (2022). A Putative Effector LtCSEP1 from Lasiodiplodia theobromae Inhibits BAX-Triggered Cell Death and Suppresses Immunity Responses in Nicotiana benthamiana. Plants, 11(11), 1462. https://doi.org/10.3390/plants11111462
